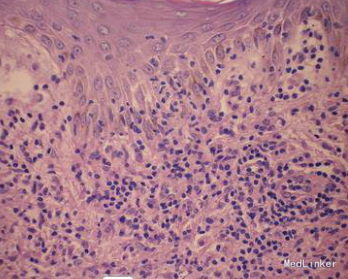
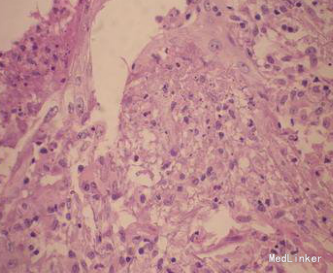

丘疹坏死性结核疹
主诉 病史
患者女,33岁,因“四肢散在红色丘疹反复4年余”就诊。患者于4年前无明显诱因四肢出现数个粟粒大红色毛囊性丘疹,不痒,偶感疼痛;1周后中央开始坏死、破溃,少许渗出或化脓;冬季自愈,部分留下瘢痕,夏季复发,如此反复,成批出现,无发热、盗汗,无咳嗽、咳痰,无胸痛、胸闷、消瘦,大小便正常。既往无结核、肝炎等病史。家族中无类似患者。系统检查未发现异常。
查体 辅查
皮肤科检查:四肢、躯干散在分布红色丘疹、结节,米粒至花生米大。部分中央破溃、结痂,部分有轻微疼痛。四肢伸侧可见淡褐色瘢痕。实验室检查:血尿常规正常,胸部x线正侧位未见异常;结核菌素试验强阳性。右上肢皮损组织病理检查:表皮稍增生,真皮炎症浸润呈楔形,真皮浅中层血管周围见淋巴细胞、组织细胞为主的炎细胞浸润。

诊断 处理
诊断:丘疹坏死性结核疹。治疗:链霉素肌肉注射,每日1次,利福平早上空腹顿服,雷米封3次/d。随访3个月后皮损全部消退,未见新出皮损,目前随访中。
随访 讨论
皮肤结核的临床表现多种多样,丘疹坏死性结核疹是其中较少见的一种。患者多为青年人,常在春秋季节发病,初发损害为毛囊性丘疹,后在丘疹顶端发生针头大小的脓疱,渐扩大,中心坏死,形成溃疡,遗留瘢痕或色素沉着。治疗方面,是否应用抗结核药物尚存在争议,总结日本多例丘疹坏死性结核疹患者没有治疗皮疹自然消退,但对于结核菌素试验阳性或合并其他结核性疾病的患者,给予正规足量的抗结核治疗是必要的。根据本例患者的典型临床表现、结核菌素试验强阳性以及组织病理学的改变,丘疹坏死性结核疹的诊断成立。给予抗结核治疗3个月后皮损消退,目前随访中。本病在发病早期皮疹主要为炎症性毛囊性丘疹,易被误诊为毛囊炎,值得注意。近来结核病的发病率已经出现了再度升高的趋势,皮肤结核病也应予高度警惕。对于可疑病人,要在认真分析临床表现的基础上,结合实验室和组织病理学检查,尽早做出诊断并给予及时正规的抗结核治疗。
